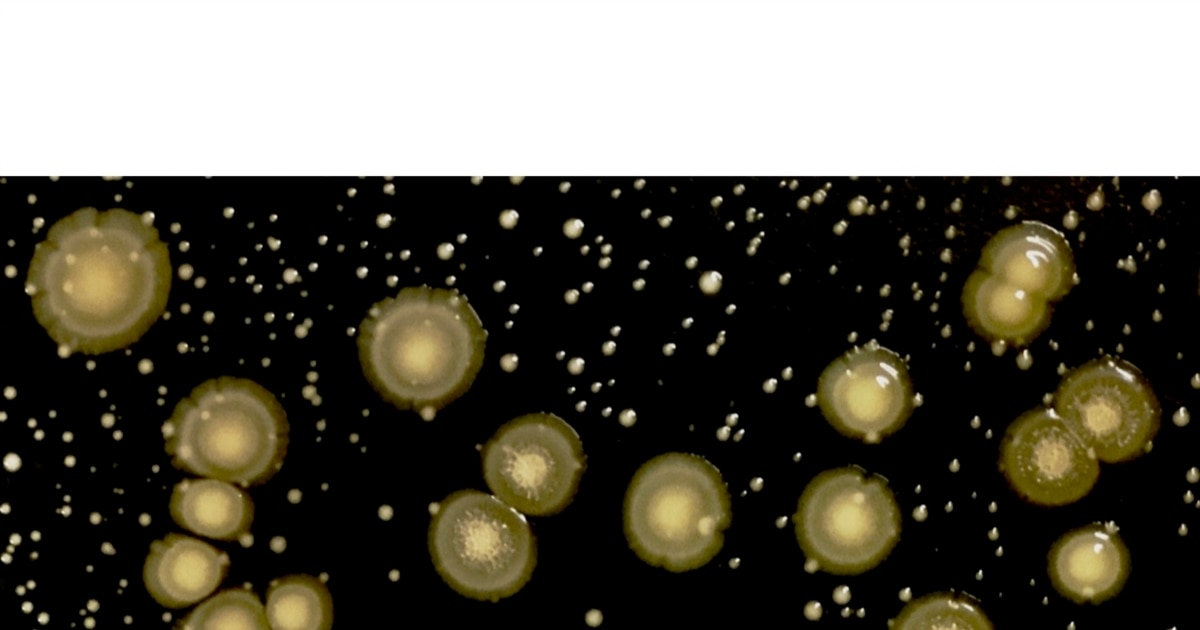

TIL George Washington prevented a military coup over unpaid back wages by putting on a pair of glasses to read a letter from Congress, explaining he was "almost blind in the service of my country.” Moved to tears, his officers compromised.
 #til #todayilearned
#til #todayilearned


Explore the Archive
The Time George Washington Prevented A Military Coup With His Glasses
As a group of disgruntled veterans gathered to protest their treatment, showing a weakness made our founding father strong.
Reddit - The heart of the internet